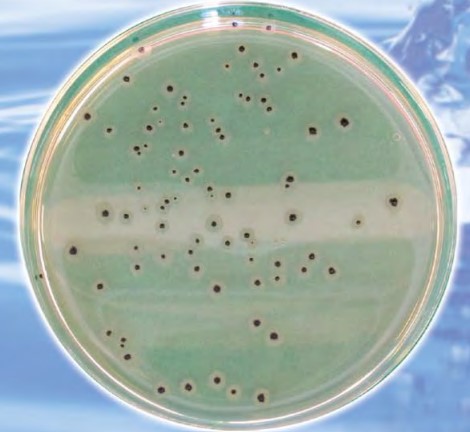
ハンドフォード培地 関東化学株式会社 イプロスものづくり

サブロー寒天培地(サブローかんてんばいち、英: Sabouraud agar)とはペプトンを含む寒天培地の一つ。サブロー寒天培地は皮膚糸状菌や他の真菌の培養に使用される。
サブロー寒天培地は1892年にRaymond Sabouraudにより作製され、その名にちなんで命名された。後にEmmonsにより他の真菌の二次培養における発育を促すためにpHを中性域に近くなるよう調整された。
脚注





サブロー寒天培地(サブローかんてんばいち、英: Sabouraud agar)とはペプトンを含む寒天培地の一つ。サブロー寒天培地は皮膚糸状菌や他の真菌の培養に使用される。
サブロー寒天培地は1892年にRaymond Sabouraudにより作製され、その名にちなんで命名された。後にEmmonsにより他の真菌の二次培養における発育を促すためにpHを中性域に近くなるよう調整された。